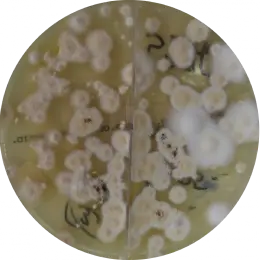
Trichophyton tonsurans
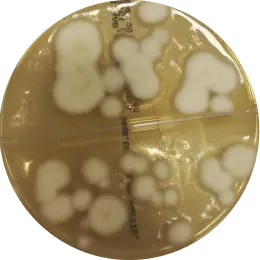
Trichophyton spp
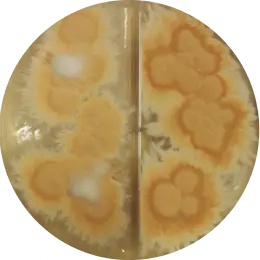
Microsporum gypseum

Grzybica - badanie w kierunku dermatofitów
Kiedy i w jakim celu
Grzyby przyczyniają się do powstawania wielu chorób, które mogą dotykać zarówno młodych jak i starszych ludzi. Wytwarzają one zarodniki, które są łatwo przenoszone na człowieka z osoby chorej lub ze zwierząt. Do rozwoju grzybicy może dojść również poprzez użytkowanie przedmiotów należących do osoby zakażonej (obuwie, odzież, meble, ręczniki). Do zakażeń szczególnie łatwo dochodzi w miejscach publicznych takich jak baseny, prysznice, siłownie, czyli tam gdzie często chodzimy bez butów.
Rozwój grzybicy mogą ułatwiać: mechaniczne uszkodzenie naskórka i płytek paznokciowych, nadmierna potliwość i zwiększona wilgotność ciała, syntetyczna lub zbyt obcisła bielizna osobista. Zwiększone ryzyko zachorowania dotyczy również sportowców oraz osób z obniżonym progiem odporności np. diabetyków, osób starszych, osób po terapii antybiotykami lub sterydami.
Dermatofity wywołują grzybicę powierzchowną. Najczęściej izolowanym w Polsce czynnikiem etiologicznym grzybicy dermatofitowej skóry i paznokci jest Trichophyton rubrum, a najczęstszą postacią zakażenia jest grzybica stóp. Prawie 40 % Polaków zmaga się z grzybicą stóp lub grzybicą paznokci stóp.
Zmiany, które mogą wskazywać na grzybicę:
- Grzybica stóp:
- przesuszona i łuszcząca się skóra
- świąd
- widoczne zaczerwienienie między palcami, grudki lub pęcherzyki
- Grzybica paznokci:
- przebarwione, pogrubione, kruche paznokcie
- utrata przejrzystości paznokcia
- oddzielanie płytki paznokcia od łożyska
- Grzybica owłosionej skóry głowy:
- rumieniowe, łuszczące się wykwity dającymi odczucie świądu, którym czasem towarzyszy wysięk ropny
- zmiany pozbawione włosów lub z charakterystycznie, równo ułamanymi włosami na wysokości kilku milimetrów ponad powierzchnią skóry, otoczonymi biało−szarą pochewką, widoczną po wyrwaniu włosa
- Grzybica skóry gładkiej:
- zaczerwienienia , z wyraźnie zaznaczonym centralnym przejaśnieniem, przesuszone i łuszczące się
- wykwity grudkowe, pęcherzykowe i krostkowe na obwodzie zmian
Badanie diagnostyczne w kierunku dermatofitów prowadzi do identyfikacji drobnoustrojów do gatunku. Właściwa identyfikacja jest niezbędna pod względem klinicznym i profilaktycznym. Pozwala ona na rozróżnienie zakażeń dermatofitowych od innych niegrzybiczych chorób jak np. łuszczyca, liszaj płaski paznokcia lub bielactwo paznokci oraz na odpowiednie dobranie leków przeciwgrzybiczych.
Przygotowanie do badań
- Odstawić leki przeciwgrzybicze:
- Leki doustne – na 3 miesiące przed badaniem,
- Preparaty miejscowe (lakiery, kremy, szampony, środki odkażające) - na co najmniej 1 miesiąc przed badaniem.
- W przypadku obecności licznych zmian chorobowych, nie stosować leczenia na żadną z nich, gdyż konieczne może być pobranie materiału z kilku miejsc.
- W przypadku podejrzenia grzybicy paznokci:
- Nie stosować lakierów i zmywaczy do paznokci – na 3-4 tyg. przed pobraniem materiału,
- Nie obcinać paznokci – na 1 tydz. przed badaniem.
- W przypadku podejrzenia grzybicy skóry:
- Co najmniej dobę przed badaniem unikać kontaktu miejsc chorobowo zmienionych ze środkami powierzchniowoczynnymi i pielęgnacyjnymi ( płyn do mycia naczyń, mydła, żele pod prysznic, szampony, kosmetyki, kremy balsamy).
- Materiał do badań pobiera wyłącznie osoba przeszkolona.
Niedopuszczalne jest samodzielne pobranie materiału przez pacjenta.
Charakterystyka!
Badanie wykonywane jest dwuetapowo manualnie:
- wykonanie preparatu bezpośredniego celem stwierdzenia obecności elementów morfotycznych grzybni hodowla na podłożach wybiórczych (do 4-ch tygodni) umożliwiająca identyfikację grzyba do gatunku
Preparaty mikroskopowe:
 Microsporum gypseum
Microsporum gypseum Scopulariopsis brevicaulis
Scopulariopsis brevicaulis Trichophyton spp
Trichophyton spp Fusarium spp
Fusarium spp Microsporum canis
Microsporum canis Trichophyton tonsurans
Trichophyton tonsuransHodowla na podłożach:
Trichophyton tonsurans
Trichophyton tonsurans Trichophyton spp
Trichophyton spp Microsporum gypseum
Microsporum gypseum Scopulariopsis brevicaulis
Scopulariopsis brevicaulisFot.
mgr Karolina Nowaczewska Pracownia Mikrobiologii, ALAB laboratoria Sp. z o.o.
mgr Przemysław Dziewirz Pracownia Mikrobiologii, Laboratoria Medyczne Grupa ALAB



